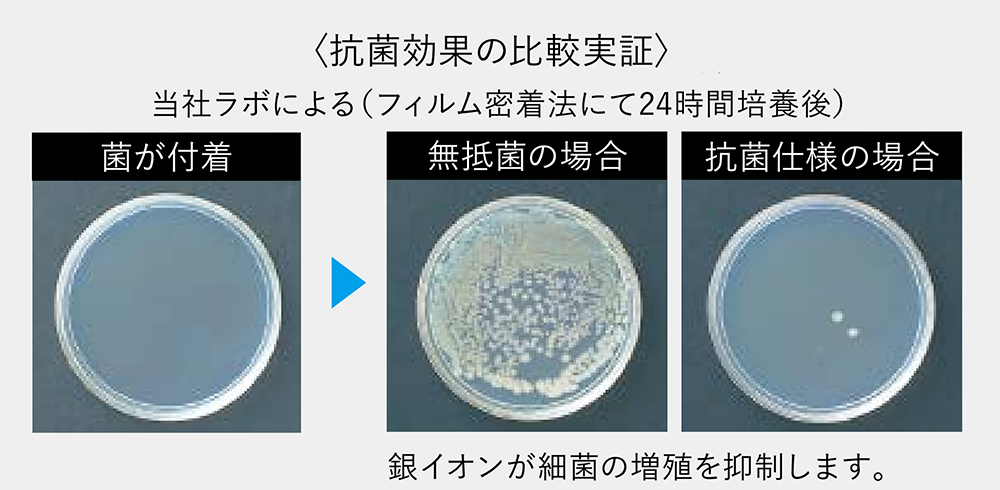
「全面」抗菌加工樹脂

#030
ハンドドライヤー ジェットタオル®

こちらは、
食堂やトイレで手を洗った後に、濡れた手を乾かしてくれるハンドドライヤーじゃ。 よく耳にする“ジェットタオル”というのは当社の商標じゃよ。
ここが便利!
使い勝手の良さは誰もが知っているとおりじゃ。使用1回あたりの電気代もごくわずかじゃ。
ここがスゴい!
最近のモデルでは、設置場所の空気もキレイにしてくれるぞ。衛生面もバッチリじゃ。




“ジェットタオル”が当社の商標であること、知りませんでした😅。私の周りは、ハンドドライヤー製品をみんな一緒に“ジェットタオル”って呼んでいます。

まぁ、そうじゃろ。ジェットタオルは1993年に世界で初めての“両面ジェットの風”でハンドドライヤー業界に革命を起こして登場して以来、国内外で多くの方々に支持されてきたハンドドライヤーのシンボル的な存在じゃ。

私、物心ついた頃から、家の近くのスーパーでジェットタオルを使うのが楽しみでした。そのスーパー、コロナ禍でジェットタオルが使用禁止になっていたのが、最近、使用が再開されたんですけど、そもそもジェットタオルって感染症拡大に影響するのかしら。

新型コロナウィルスは、感染者の飛沫(くしゃみ、咳、つばなど)と一緒に放出され、他者がそのウイルスを口や鼻から直接吸い込んで感染するとされているんじゃ。

ジェットタオルって、使用者の手に空気を送っているだけで、感染者の飛沫を飛散させているわけではないですよね。

そのとおり。そのため当社はジェットタオルの使用が、他の乾燥手段に比べて感染リスクを高める要因にはならないと考えておるんじゃ。ちゃんと手を洗って、ジェットタオルを正しく使って、定期的に適切に清掃していれば問題ないんじゃ。

詳しくはコチラをご覧あれ。

安心しました! ジェットタオルって、便利なだけでなく、コストも安いって聞いていますので、これからもどんどん使いたいと思います。

そのコストじゃが、1回使用するのにかかる電気代って、どのくらいか知っておるか。

え~っと、ペーパータオルよりは安いとすると、1回1円くらい、とか. . .?

ん~、残念! 機種によって変わるが、例えば最近のJT-SB116LHという機種の場合、1日400回使用したとして、1日の電気代は約20円。つまり1回あたり約0.05円じゃ。

詳しくはコチラをご覧あれ。

え~っ! びっくり~! そんなに使って、たったそれだけですか。

もともとそんなに安かったわけではないぞ。ジェットタオルは2023年で発売から30周年。この間、大きくスペックが進化しておるぞ。こんな感じじゃ。


消費電力だけでなく、風の出る量や当たり方が進化して乾燥時間が短くなったり、運転音が静かになったりしているんですね。

それだけではないぞ。機能面も大きく進化しておる。一例として「衛生強化モデル」を紹介しよう。ズバリ、手を乾かすだけでなく、ジェットタオルを設置している空間の空気を24時間、循環洗浄するんじゃ。こんな感じじゃ。
音声無し、29秒

すご~い! トイレの気になるニオイにも効果がありそうですね。

もちろんじゃ。他にも本体樹脂の衛生性がアップしていたり、手を乾かしているときに、利用者へ水滴が飛び散るのを抑制する機能を加えたりして、衛生面を徹底的に強化しておるんじゃ。

「衛生強化モデル」、私の家にも欲し~い!

まぁ、このタイプは企業が導入するのが一般的じゃが、もちろん自宅に導入することもできるぞ。これから先、手を洗った後は、ジェットタオルにずっと頼るのもいいかも. . .じゃ。

博士、、、寒い!? 。😊
ジェットタオルの特長
◆両側面から手を入れることが可能。「サイドオープン設計」
両側面が開放された独自のスタイル。だからとても使いやすく、お掃除もしやすい!
両側面を開放したサイドオープン設計により、横から自然に手を挿入でき、側面に手が触れそうな圧迫感を解消しました。手を横から入れ、上へゆっくり引き出す動作を数回くりかえすだけで、より正確に速く乾かせます。

◆使う回数が多くても安定作動。「DCブラシレスモーター」
当社は、1日600回の使用で7年間(目安)の耐久性を誇るDCブラシレスモーターを搭載。ブラシとローターに磨耗が発生しないので効率よくパワーを発揮でき、長期間の安定した作動を維持します。
DCブラシレスモーター:
スリムタイプ(衛生強化モデル/速乾モデル)に採用。
整流子モーター:
スリムタイプ(標準モデル)、ジェットタオルミニ、ジェットタオルプチに採用。


◆菌の繁殖も本体全面で抑制。「全面※1」抗菌加工樹脂※2
多くの方が気になる菌の繁殖にもスキのない対策を施しています。手挿入部やドレンタンク・ドレン水路はもちろん、本体全面※1に抗菌加工樹脂を採用し、いつでも気持ちよくお使いいただけます。
- スリムタイプ(衛生強化モデル)の場合:背面部、底面部、メンテナンスパネル内部を除く。
スリムタイプ(速乾モデル・標準モデル)の場合:背面部、底面部、スイッチドア内部を除く。
ジェットタオルミニの場合:背面部、ノズル部、スイッチカバー内部を除く。
ジェットタオルプチ壁取付タイプの場合:ノズル部、センサー部、天面シート、取付板を除く。 - SIAA抗菌マーク(ISO22196)を取得。
取材協力

三菱電機株式会社 中津川製作所
換気送風機製造部 産業機器技術課
小林 章樹

「小林さん、ジェットタオルの開発に携わって印象に残ったことを一言お願いします。」

開発当時はコロナ禍でハンドドライヤーが利用停止となっていましたが、専門家の先生方にも意見を伺い、衛生性に特化した商品コンセプトを練り上げました。それと並行して、新型コロナウイルスに関する論文や科学的知見も調査し、ハンドドライヤーの使用が感染リスクを高める要素が極めて少ないことも実験とシミュレーションを用いて検証しました。昨年10月にようやく、科学的根拠をもとにハンドドライヤーの利用が問題ないと判断され、利用が再開されており、出かけた先でジェットタオルが活躍していると大変嬉しく、また誇りに思います。今後も利用者に安全・安心を提供する製品開発に努めていきたいと思います。




